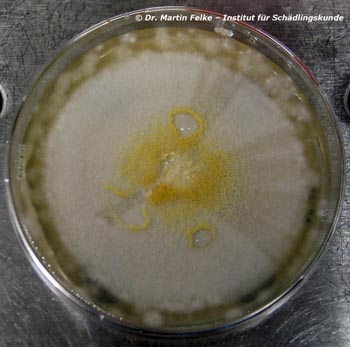
Abbildung 3: Auf Taubenkot wachsen auch Schimmelpilze der Gattung Aspergillus

Straßentauben sind fast immer mit Viren, Bakterien, Einzellern oder anderen Parasiten infiziert, die prinzipiell auch dem Menschen gefährlich werden können. Man spricht in diesem Fall von sog. humanpathogenen Krankheitserregern. An dieser Stelle möchten wir Ihnen vor allem Viruserkrankungen, bakterielle Krankheiten und durch Pilze hervorgerufene Erkrankungen vorstellen, die von Straßentauben auf den Menschen übertragen werden können.
Bislang wurden bei Straßentauben sechs humanpathogene Viruskrankheiten nachgewiesen. Dies waren Influenza (Echte Grippe), Paramyxovirose, Röteln, St. Louis Enzephalitis, Western Equine Encephalomyelitis und West Nil Virus. Allerdings konnte bislang noch keine Virus-Übertragung von infizierten Tauben auf den Menschen zweifelsfrei belegt werden. Besonders interessant für den Schädlingsbekämpfer ist die Frage, ob Tauben die auch für den Menschen gefährliche Form der Vogelgrippe übertragen können. Die Vogelgrippe ist eine seit mehr als einhundert Jahren bekannte Erkrankung bei Vögeln, die weltweit verbreitet ist. Sie wird vom Influenza-A-Virus verursacht, das in 16 Unterarten auftritt. Der aus Asien stammende Influenza-A-Subtyp H5N1 ist u. a. für Hühner und Enten hoch ansteckend und auch Menschen können an diesem Virus erkranken. Tauben kommen ebenfalls als Vektoren für die Übertragung von Influenza-A-Viren in Frage. Im Jahre 2002 wurde das H5N1-Virus erstmals bei einer toten Straßentaube in Hong Kong nachgewiesen. Laboruntersuchungen zeigten aber, dass Straßentauben für das H5N1-Virus nur wenig empfänglich sind und das Virus daher vermutlich auch nur selten weitergeben dürften. Dass dies aber nicht völlig ausgeschlossen werden kann, zeigt eine Beobachtung aus Thailand. Hier wurde eine an H5N1 erkrankte Hauskatze gefunden, die zuvor eine tote Straßentaube gefressen hatte. In der Umgebung wurden anschließend mehrere tote Straßentauben aufgesammelt, bei denen das H5N1-Virus ebenfalls nachgewiesen wurde. Nach den bislang vorliegenden Informationen besteht zwar derzeit keine Gefahr, dass es in Straßentauben-Populationen zum Ausbruch von Vogelgrippe-Epidemien kommen könnte. Falls das humanpathogene H5N1-Virus allerdings so mutieren sollte, dass es für Tauben hoch infektiös werden würde, müssten geeignete Maßnahmen ergriffen werden, um die Bevölkerung vor einer Ansteckung zu schützen. Schädlingsbekämpfer können sich vor einer möglichen Ansteckung mit dem Vogelgrippevirus am besten durch das Anlegen von Schutzkleidung und Atemschutzmaske schützen, wenn sie Taubenkot beseitigen oder Taubenabwehrmaßnahmen durchführen.
Eine andere Viruserkrankung, die häufig bei Straßentauben nachgewiesen wird, ist die Paramyxovirose. Eine Übertragung der Paramyxovirose von Straßentauben auf den Menschen wurde bislang zwar noch nicht beschrieben, scheint aber durchaus möglich zu sein. Da Stämme vom Paramyxovirus Typ I für Hühner ansteckend sind, besteht außerdem die Gefahr dass die Erkrankung von verwilderten Haustauben auf Geflügel übertragen wird.
Bei Straßentauben kommen mindestens 41 humanpathogene Bakterienarten bzw. Serovare vor. Für drei dieser Pathogene konnte bislang eine Übertragung von infizierten Tauben auf den Menschen nachgewiesen werden. Es handelt sich dabei um Salmonella enterica, den Erreger der Salmonellose, Coxiella burnetti, den Erreger des Q-Fiebers, sowie um Chlamydophila psittaci, den Erreger der Ornithose.
Die häufigste, von Tauben übertragene bakterielle Erkrankung ist die Ornithose oder Papageienkrankheit, die durch das Bakterium Chlamydophila psittaci verursacht wird. Im Rahmen zahlreicher, weltweit durchgeführter Studien wurden durchschnittlich bei 44,6 % der untersuchten Tauben Antikörper gegen Chlamydophila psittaci gefunden. Somit kam fast die Hälfte der untersuchten Vögel im Laufe ihres Lebens mit dem Erreger in Kontakt. Dieser hohe Wert lässt sich damit erklären, dass das Bakterium regelmäßig von den Altvögeln an die Nestlinge weitergegeben wird. Chlamydophila psittaci kommt v. a. bei Vögeln aber auch bei Katzen, Hunden, Ziegen, Schafen oder anderen Haustieren vor. Bakterienstämme von Vögeln, insbesondere von Papageienartigen weisen eine höhere Humanpathogenität auf als Stämme anderer Tiergruppen. Vögel spielen als Infektionsquelle für den Menschen die wichtigste Rolle (daher auch der Begriff "Ornithose"). Chlamydophila psittaci ist ein intrazellulär lebender Parasit und wird von infizierten Tieren z. B. mit dem Kot ausgeschieden. Das Bakterium kann in Staub, getrocknetem Kot oder auf Federn mehrere Monate außerhalb des Wirtes überleben. Bei Raumtemperatur kann Chlamydophila psittaci selbst bei Austrocknung ungefähr vier Wochen infektiös bleiben. Infizierte Vögel müssen selbst nicht unbedingt Krankheitssymptome zeigen. Dennoch scheiden sie den Erreger v. a. mit dem Kot aus.
Menschen infizieren sich mit der Ornithose v. a. durch das Einatmen von kontaminiertem Staub, z. T. aber auch nach direktem Kontakt mit infizierten Tieren, bzw. deren Ausscheidungen. Bis zum Ausbruch der Krankheit vergehen beim Menschen zwischen vier und 15 Tage, in Extremfällen bis zu einem Monat. Vor Einführung der Antibiotika starben rund 40 Prozent der Erkrankten. Heute sind Todesfälle zwar mit einem Prozentsatz von unter fünf Prozent selten, die Krankheit nimmt aber immer noch häufig einen schweren Verlauf. Das Krankheitsbild ist vielfältig - fast jedes Organ kann betroffen sein. Vorherrschend ist eine fieberhafte Lungenentzündung. Daneben können Kopf-, Muskel- und Gelenkschmerzen, eine Lebervergrößerung und Entzündungen des Herzens, des Gehirns und der Bindehäute auftreten. Bis heute wurde die Übertragung der Ornithose von Straßentauben auf den Menschen 101-mal dokumentiert. In zwei Fällen nahm die Erkrankung dabei einen tödlichen Ausgang. Schädlingsbekämpfer gehören berufsbedingt zu den Personengruppen, für die ein besonders hohes Risiko besteht sich mit der Papageienkrankheit anzustecken. Besonders bei der mechanischen Beseitigung von getrocknetem Taubenkot auf Dachböden entstehen große Mengen an Staub, der hochgradig mit dem Erreger der Papageienkrankheit kontaminiert sein kann. Wird dieser Staub eingeatmet, so ist das Risiko an Ornithose zu erkranken relativ hoch. Nur die konsequente Verwendung von persönlicher Schutzausrüstung (PSA), sowie die Benutzung einer Partikel filtrierenden Atemschutzmaske (FFP2) bietet unter solchen Umständen Schutz davor an der Papageienkrankheit zu erkranken.
Eine weitere bakterielle Erkrankung, die von Straßentauben auf den Menschen übertragen werden kann, ist das Q-Fieber (englisch: Query fever), welches durch das Bakterium Coxiella burnetii verursacht wird. Das Bakterium kommt in zahlreichen Vogel- und Säugetierarten vor. Coxiella burnetii konnte häufig auch aus Läusen, Milben, Fliegen sowie über 40 Zeckenarten isoliert werden. Zecken gelten zugleich als Reservoir wie auch als wichtige Vektoren (Überträger) des Erregers. So konnte zweifelsfrei belegt werden, dass der Kontakt mit Coxiella burnetii-infiziertem Taubenkot und Taubenzecken den Ausbruch von Q-Fieber beim Menschen verursachen kann. Das Bakterium vermehrt sich in den Zellen seines Wirtsorganismus. Außerdem besitzt es die Fähigkeit Dauerformen zu bilden wodurch es z. B. in Staub, auf Heu oder Wolle jahrelang überleben kann. Coxiella burnetii wird v. a. durch Inhalation von infektiösem Staub oder durch direkten Kontakt zu infizierten Tieren übertragen. Aus diesem Grund sollte bei der Beseitigung von Taubenkot, der potenziell Dauerformen von Coxiella burnetii enthalten kann, unbedingt auf entsprechende Schutzmaßnahmen geachtet werden. Eine Infektion von Menschen, die durch das Einatmen von Coxiella burnetii-haltigem Staub ausgelöst wurde, wurde schon bis zu zwei Kilometer entfernt von infizierten Tierherden verzeichnet.
Beim Menschen vergehen zwischen zwei bis drei Wochen bis die Krankheit ausbricht. Rund die Hälfte aller Infektionen verlaufen unbemerkt oder mit milden, grippeähnlichen Symptomen und heilen in ein bis zwei Wochen wieder aus. Die akute Infektion beginnt meist mit hohem Fieber, Schüttelfrost, Muskelschmerzen und ausgeprägten Stirnkopfschmerzen. Im weiteren Verlauf können Lungen- oder Leberentzündung hinzukommen. Seltener sind Herzmuskel- oder Hirnhautentzündungen. Ungefähr ein Prozent aller Infektionen verlaufen chronisch. Unter Umständen kann der Erreger in bestimmten Zellen im Blut, den sog. Makrophagen überleben. In diesen Fällen kann die Krankheit spontan wieder ausbrechen. Dies geschieht v. a. während der Schwangerschaft oder wenn das Immunsystem der betroffenen Personen geschwächt ist.
Salmonellosen sind Erkrankungen, die durch Bakterien der Gattung Salmonella verursacht werden und vorwiegend den Darm betreffen. Salmonellen kommen weltweit unter anderem in Geflügel, Schweinen, Rindern, aber auch in Reptilien vor. Sie werden meist durch den Verzehr verunreinigter Lebensmittel auf den Menschen übertragen. Bisher wurden über 2.000 verschiedene Salmonella-Serotypen gefunden. Bei Straßentauben wurden bis heute 19 dieser Serotypen nachgewiesen. Eine Salmonellen-Erkrankung bricht in der Regel 12 bis 72 Stunden nach Aufnahme der Salmonellen aus. Charakteristisch für das Krankheitsbild ist wässriger Durchfall. Daneben können auch Bauchschmerzen, Übelkeit, Erbrechen und Fieber auftreten. Die Symptome dauern in der Regel nur wenige Stunden oder Tage an. Bei einer in Kroatien durchgeführten Studie waren bis zu 15 Prozent der untersuchten Straßentauben mit Salmonellen infiziert. Der definitive Nachweis einer Salmonellen-Übertragung von verwilderten Haustauben auf den Menschen gelang bislang erst einmal. Hier kam es zu einer Infektion mit Salmonella enterica (Serotyp Kiambu). Vermutlich spielen Straßentauben bei der Übertragung von Salmonellen aber eine wesentlich größere Rolle.
Um sich vor einer Ansteckung mit Salmonellen und Coxiella burnetii (Q-Fieber) zu schützen sollten Schädlingsbekämpfer bei der Beseitigung von Taubenkot oder bei der Durchführung von Taubenabwehrmaßnahmen eine komplette persönliche Schutzausrüstung (PSA) anlegen, eine Partikel filtrierende Atemschutzmaske (FFP2) anlegen und am Arbeitsplatz weder essen noch rauchen.

Abbildung 1: Können Straßentauben (Columba livia domestica) die Vogelgrippe übertragen? (Foto: S. Feiertag)

Abbildung 2: Die Papageienkrankheit wird auch von Straßentauben (Columba livia domestica) übertragen (Foto: S. Feiertag)
Mykosen sind Erkrankungen, die durch Pilze verursacht werden. Mindestens 55 humanpathogene Pilzarten wurden bislang im Kot, bzw. direkt im Körper der Straßentauben nachgewiesen. Für vier dieser Pathogene konnte bislang eine Übertragung von infizierten Tauben auf den Menschen nachgewiesen werden. Es handelt sich dabei um Cryptococcus neoformans, den Erreger der Cryptococcose, Histoplasma capsulatum, den Erreger der Histoplasmose, Candida parapsilosis, den Erreger der Candidose, sowie um Schimmelpilze der Gattung Aspergillus, die die sog. Aspergillose hervorrufen.
Die Pilze, die diese Krankheiten auslösen, leben meist im Taubenkot, oder aber im Erdreich. Sie gelangen hauptsächlich dann in den menschlichen Körper, wenn Fruchtkörper der Pilze oder aber Pilzsporen inhaliert werden. Die genannten Pilzarten gehören zu den sog. opportunistischen Erregern, die hauptsächlich Menschen mit geschwächtem Immunsystem befallen. Besonders gefährlich ist eine Erkrankung durch Schimmelpilze der Gattung Aspergillus. In mindestens 13 Fällen wurden derartige Schimmelpilze von erkrankten Straßentauben auf den Menschen übertragen. Neun der erkrankten Patienten starben später an Aspergillose. Schädlingsbekämpfer gehören berufsbedingt zu den Personen, die besonders häufig mit Taubenkot und den darin enthaltenen humanpathogenen Pilzsporen in Berührung kommen. Um eine Ansteckung mit gefährlichen Mykosen zu vermeiden, sollten sich Schädlingsbekämpfer bei der Beseitigung von Taubenkot oder Taubenkadavern unbedingt vor dem Einatmen von Pilzsporen durch die Verwendung einer effizienten Atemschutzmaske schützen.
Cryptococcus neoformans, der Erreger der Cryptococcose ist ein weltweit verbreiteter Hefepilz. Der Pilz kann beim Menschen und anderen Säugern, nicht aber bei Tauben eine Infektion verursachen. Da Taubenkot ein geeignetes Substrat für das Wachstum von Cryptococcus neoformans darstellt, fungieren Tauben als mechanische Träger des Erregers. Generell gelten Taubenkot, sowie mit Taubenkot verunreinigte Erde als die wichtigsten natürlichen Infektionsquellen für Cryptococcose. In einer spanischen Studie konnte Cryptococcus neoformans auch direkt in der Kloake von verwilderten Haustauben nachgewiesen werden. In verschiedenen Untersuchungen lag der Prozentsatz, mit dem Cryptococcus neoformans in Taubenkot nachgewiesen werden konnte, zwischen sechs und 87,5 Prozent. Der Mensch infiziert sich mit Cryptococcose hauptsächlich durch das Einatmen von Staub, der mit Cryptococcus neoformans kontaminiert ist. Daneben kann eine Infektion über den Darm oder die Haut erfolgen. Eine Übertragung von Mensch zu Mensch kann ausgeschlossen werden. Im Körper verbreitet sich der Erreger über Blut und Lymphe. Die Krankheit bricht in der Regel nur bei Immungeschwächten Personen, wie z. B. AIDS-Patienten aus. Die primäre Cryptococcose der Lunge selbst ist in der Regel symptomlos, führt aber zur Streuung in den übrigen Körper, v. a. ins Zentralnervensystem mit der Folge einer Hirnhautentzündung. Auch Haut- und Schleimhaut-Infektionen treten häufig bei Cryptococcose häufig auf.
Histoplasma capsulatum, der Erreger der Histoplasmose, wurde bislang bei mindestens zwei Gelegenheiten von Straßentauben auf den Menschen übertragen. Insgesamt erkrankten dabei 91 Personen an Histoplasmose. Die Histoplasmose ist eine Infektionskrankheit, bei der vorwiegend die Lunge befallen wird. Die Ansteckung mit dem im Erdboden oder in Vogelkot lebenden Pilz erfolgt durch Einatmen der Sporen. Über den Blutkreislauf kann Histoplasma capsulatum auch in Lymphknoten, Leber und Milz eindringen.
Die Aspergillose ist eine durch Pilze der Gattung Aspergillus hervorgerufene Erkrankung. Aspergillose tritt meist nur bei älteren Menschen oder bei Patienten mit geschwächtem Immunsystem auf. Durch Einatmen der Pilzsporen entsteht eine Entzündung der Atemwege, die sich entweder in Form einer Allergie oder als Bronchitis bzw. Lungenentzündung äußert. Pilze der Gattung Aspergillus können auch außerhalb der Lunge zu Entzündungen führen, wie z. B. im Gehirn oder im Magen-Darm-Trakt. Seltener werden auch Haut, Ohren oder Herzklappen befallen. Die Aspergillose wird mit sog. Antimykotika behandelt.
Candida parapsilosis, der Erreger der Candidose, wurde erwiesenermaßen 12-mal von erkrankten Straßentauben auf den Menschen übertragen. Die sog. Candidose ist eine Infektion der Haut, der Schleimhäute oder der inneren Organe mit Hefepilzen aus der Gattung Candida. Während eine Candida-Infektion der Haut meist problemlos heilbar ist, können Infektionen von inneren Organen sogar tödlich verlaufen. Besonders bei Menschen mit geschwächtem Immunsystem wie z. B. HIV-Patienten können Lungen, Herz, Magen, Darm, Leber, Milz und das Zentralnervensystem betroffen sein. Kandidosen, die den gesamten Organismus betreffen verlaufen in 70 % aller Fälle tödlich.
In verschiedenen Untersuchungen konnten bislang sechs potenziell humanpathogene Einzellerarten bei Straßentauben nachgewiesen werden. Eine Übertragung dieser einzelligen Parasiten von der Taube auf den Menschen ist v. a. bei einem direkten Kontakt mit erkrankten Tieren möglich. Eine Übertragung von der Taube auf den Menschen konnte bislang lediglich für den Einzeller Toxoplasma gondii belegt werden, der die sog. Toxoplasmose hervorruft. Dieser Parasit vermehrt sich v. a. in Zellen des Zentralnervensystems, der Leber, der Milz sowie der Lunge. Die Toxoplasmose stellt besonders während der Schwangerschaft ein besonderes Problem dar, da eine Übertragung der Parasiten auf das ungeborene Kind möglich ist. Im schlimmsten Fall stirbt der Embryo noch im Mutterleib ab, oder das Neugeborene kommt mit schweren Schäden zur Welt. Werden Erwachsene von Toxoplasma gondii infiziert, können sich viele Monate oder Jahre später Schäden einstellen, die besonders das Zentralnervensystem und die Augen (Erblindung) betreffen. Erste Symptome einer Toxoplasmose sind Fieber, Müdigkeit, Mattigkeit, Kopfschmerzen, Muskel- und Gliederschmerzen oder Durchfälle. Häufig befällt der Erreger auch die Lymphknoten.
Abbildung 3: Auf Taubenkot wachsen auch Schimmelpilze der Gattung Aspergillus

Abbildung 4: Um sich vor einer Ansteckung mit Krankheitserregern zu schützen, sollten Schädlingsbekämpfer bei der Beseitigung von Taubenkot oder Taubenkadavern unbedingt persönliche Schutzausrüstung (PSA) und Atemschutzmaske tragen.
Straßentauben sind z. T. von Bandwürmern (Cestoden), Fadenwürmern (Nematoden) und Saugwürmern (Trematoden) befallen. Eine Übertragung dieser Parasiten von der Taube auf den Menschen ist zwar denkbar, wurde allerdings bislang noch nicht zweifelsfrei belegt. Bislang wurden drei Bandwurmarten, neun Arten von Fadenwürmern und eine Saugwurmart bei Tauben nachgewiesen. Die Parasiten leben in verschiedenen Organen ihres Wirtsorganismus und geben ihre Eier über den Kot ab. Der Mensch kann sich somit durch die Aufnahme von Taubenkot auch mit den verschiedenen bei Tauben vorkommenden parasitischen Würmern infizieren.
Bandwürmer (Cestoden) leben stets parasitisch im Darm ihrer Wirtsorganismen. Ihr Körper besteht aus einem sog. Skolex und zahlreichen, gleichförmig erscheinenden Körpergliedern, die als Proglottiden bezeichnet werden. Die Wachstumszone hinter dem Skolex, der als Verankerungsorgan im Wirtsdarm dient, liefert fortlaufend neue Proglottiden, die alle ein vollständiges, zwittriges Geschlechtssystem besitzen. Proglottiden mit voll entwickelten Eiern lösen sich vom Rest des Tieres ab und werden zusammen mit dem Kot des Wirtsorganismus ausgeschieden. Wird dieser infizierte Kot beispielsweise über verunreinigte Nahrung von einer anderen Taube oder aber auch von einem Menschen aufgenommen, so schlüpfen aus den Bandwurmeiern im Darm des neuen Wirtes neue Parasiten und ein neuer Vermehrungszyklus beginnt. Bei Straßentauben kommt unter anderem die Bandwurmart Aporina delafondi vor. Geschlechtsreife Individuen dieses weltweit verbreiteten Parasiten erreichen eine Körperlänge von rund 15 cm.
Wesentlich häufiger als von Bandwürmern werden Tauben von Fadenwürmern (Nematoden) befallen. Bislang wurden neun Nematodenarten in verwilderten Haustauben nachgewiesen. Eine dieser Arten ist Capillaria columbae. Die ausgewachsenen Fadenwürmer leben in der Darmschleimhaut ihrer Wirte, wo sie eine Schädigung und Ablösung der Darmschleimhaut hervorrufen. Die Weibchen der Fadenwürmer produzieren eine große Anzahl von Eiern, die mit dem Kot befallener Tauben ins Freie gelangen. Zu diesem Zeitpunkt enthalten die Eier noch keine Embryonen. Unter Laborbedingungen reiften bei einer Temperatur von 30°C innerhalb von sechs bis sieben Tagen in den Eiern Embryonen heran. Wurden die Eier in diesem Stadium an Hühner verfüttert, so schlüpften die Embryonen innerhalb von 24 Stunden und ließen sich in der Darmschleimhaut ihrer Wirtsorganismen nachweisen. In nur 21 Tagen wuchsen die Parasiten dann zu geschlechtsreifen Individuen heran und zu dieser Zeit ließen sich erstmals Nematoden-Eier im Kot parasitierter Wirte finden. Ganz ähnlich ist der Lebenszyklus der Fadenwurmart Ascaridia columbae, die ebenfalls bereits bei verwilderten Haustauben nachgewiesen wurde. Eine Übertragung von Fadenwürmern von befallenen Tauben auf den Menschen ist denkbar, wenn Nahrungsmittel verzehrt werden, die vom Kot erkrankter Straßentauben verunreinigt wurden.
Saugwürmer (Trematoden) fielen bei der Untersuchung von Straßentauben bislang kaum auf. Lediglich in einer einzigen Studie wurde die Trematodenart Echinoparyphium recurvatum in einer verwilderten Haustaube nachgewiesen. Dies kann entweder bedeuten, dass ein Saugwurmbefall bei verwilderten Haustauben recht selten auftritt, oder aber entsprechende Untersuchungen bislang nicht systematisch durchgeführt wurden. Eine Übertragung von Saugwürmern von erkrankten Straßentauben auf den Menschen wurde bislang nicht nachgewiesen, ist aber denkbar, falls mit der Nahrung Taubenkot aufgenommen wird, der Saugwurmeier enthält. Ein Befall des Menschen mit Saugwürmern wird als Echinostomiasis bezeichnet. Meist verläuft diese Erkrankung unbemerkt. Bei starkem Befall können Leibschmerzen, Durchfälle und eventuell auch Blutarmut auftreten.
Anmerkung: Dieser Artikel erschien in der Maiausgabe 2010 des DpS (Der praktische Schädlingsbekämpfer)